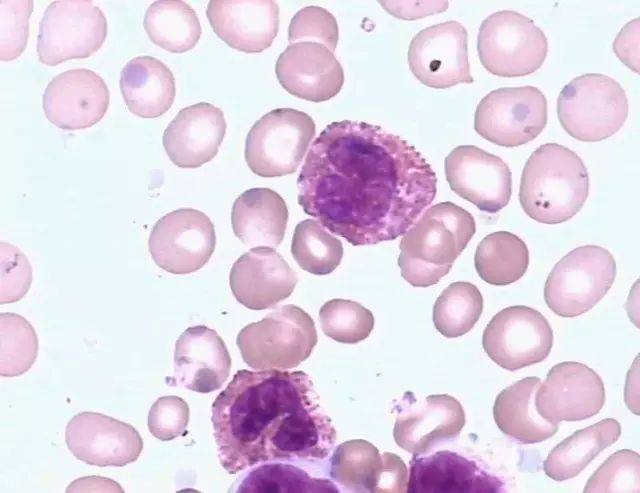
【临床】粒细胞系统各阶段细胞形态

粒细胞系统形态图

粒细胞系统
图片尺寸1080x1139
临检检验科血细胞形态
图片尺寸1080x821
【形态学学习】第一期 粒系_粒细胞
图片尺寸960x379
白细胞 红细胞 人的血细胞彩图 血小板
图片尺寸1080x810
不同发育阶段的粒细胞形态图片 生命经纬知识库
图片尺寸494x361
【形态学学习】第一期 粒系_粒细胞
图片尺寸960x720
正常血细胞形态粒细胞
图片尺寸335x219
【形态学学习】第一期 粒系_粒细胞
图片尺寸960x720
新正常粒细胞形态ppt学习教案
图片尺寸920x690
166
图片尺寸1080x810
02形态特征:该类细胞胞体增大,中性分叶核粒细胞的核分叶超过5叶,粒
图片尺寸750x563
上面三张照片所选的观察部位并不适合进行白细胞形态学的观察,这里红
图片尺寸800x612
其它 血液细胞形态学检查 写美篇白细胞异常形态 颗粒增多:感染,粒
图片尺寸720x487
【形态学学习】第一期 粒系_粒细胞
图片尺寸960x727
【形态学学习】第一期 粒系_粒细胞
图片尺寸589x383
临床基本功│粒细胞正常与异常形态
图片尺寸480x480
各种白细胞的形态
图片尺寸1179x1130
【临床】粒细胞系统各阶段细胞形态
图片尺寸640x493
某些防御感染的白细胞巨噬细胞与中性粒细胞常在一起起作用:巨噬细胞
图片尺寸450x525
【形态学学习】第一期 粒系_粒细胞
图片尺寸720x525